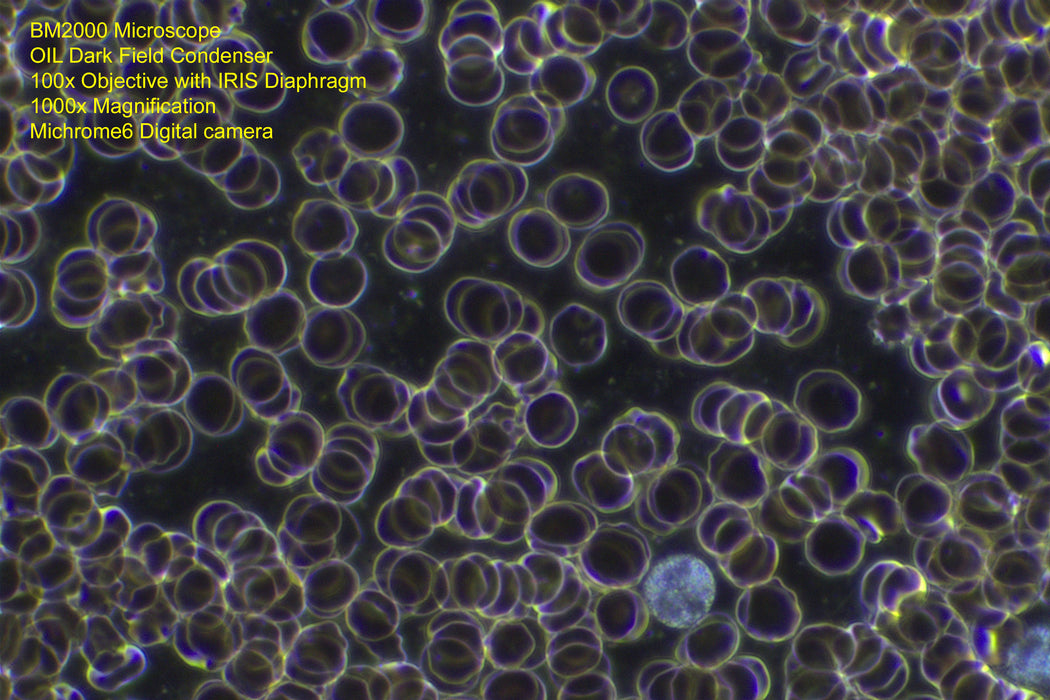

BM2000 Dark Field Condenser OIL
OIL Dark Field Condenser for the Optico BM2000 Laboratory Microscope
Darkfield microscopy uses refracted light to make live specimens such as pond life microorganisms or blood appear with bright contrast against a dark (black) background. By blocking out the centre of the transmitted (bottom) light of your microscope and not allowing direct rays to enter the objective lens, only the outer rays of light strike the specimen.
Put 1-2 drops of immersion oil onto the top of the OIL condenser and raise it until the oil contacts the underside of the slide for the sharpest dark field imaging, much sharper than using a DRY dark field condenser.
Dark field will not work with a standard 100x objective because of the high numerical aperture, for 1000x magnification you will need to purchase the optional 100x Infinity Plan Dark Field objective with built-in IRIS Diaphragm for the ultimate in dark field viewing.
- Dark Field Condenser: Oil
- NA (Numerical Aperture) : 1.36-1.25
- Suitable for our BM2000 Microscope only